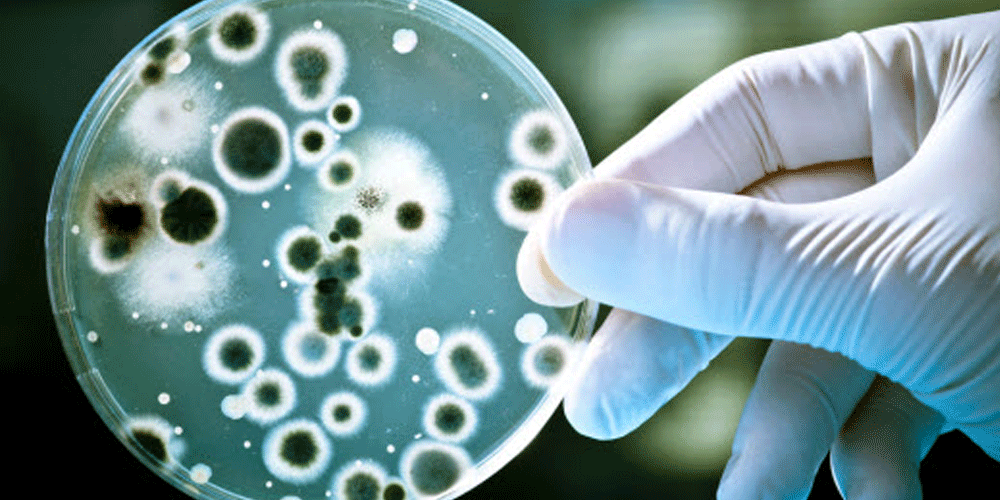

माओवादीमा विधि, पद्धति र प्रक्रियालाई कडाइका साथ लागू गर्न नेताहरूको सुझाव
काठमाडौं । नेकपा माओवादी केन्द्रको स्थायी कमिटी बैठकमा नेताहरूले पार्टीभित्र विधि, पद्धति र प्रक्रियालाई कडाइका साथ लागू गर्न सुझाव दिएका छन् । शनिवार पार्टी कार्यालय पेरिसडाँडामा बसेको बैठकमा नेताहरूले पार्टीलाई एकताबद्ध रूपमा अघि बढाउन विधि र प्रक्...

सरकारले कानुन बनाएर विदेशी सेना नेपाल ल्यायो : भीम रावल
काठमाडौं । पूर्वउपप्रधानमन्त्री डा. भीम रावलले सरकारले कानुन बनाएर विदेशी सेनालाई नेपाल प्रवेश गर्न बाटो खोलेको आरोप लगाएका छन् । शनिबार काठमाडौंमा आयोजित एक कार्यक्रममा उनले यस्तो दाबी गरेका हुन् । उनले भने, ‘मैले सुनेको छु, एउटा कानुन ल्याइएको छ ।...

जबरजस्ती करणीको आरोपमा एक जना पक्राउ
दाङ । घोराही उपमहानगरपालिका-१८ नवलपुरका २३ वर्षीय सन्तोष वलीलाई १६ वर्षीया बालिकामाथि जबरजस्ती करणी गरेको आरोपमा प्रहरीले बिहीबार राति पक्राउ गरेको छ । जिल्ला प्रहरी कार्यालय दाङले प्राप्त उजुरीका आधारमा वलीलाई पक्राउ गरेको हो । घटनाबारे प्रहरीले थप ...

राष्ट्रपति पौडेल र प्रधानमन्त्री ओलीबीच भेटवार्ता
काठमाडौं । राष्ट्रपति रामचन्द्र पौडेल र प्रधानमन्त्री केपी शर्मा ओलीबीच भेटवार्ता भएको छ । शनिवार राष्ट्रपति भवन शीतलनिवासमा भएको भेटमा उनीहरूले सरकारको पछिल्लो कार्यप्रगति र देशको वर्तमान राजनीतिक अवस्थाबारे छलफल गरेका छन् । प्रधानमन्त्री ओलीले राष...

करेन्ट लागेर एक बालकको मृत्यु
बैतडी । करेन्ट लागेर आज यहाँ एक बालकको मृत्यु भएको छ । मृत्यु हुनेमा डिलाशैनी गाउँपालिका(३ गिरीबगर निवासी केशव कोलीका १३ वर्षीय छोरा किरण कोली रहेको प्रहरीले जनाएको छ । आज दिउँसो स्थानीय डिन्नीगाड खोलामा बालुवा सङ्कलन गर्न गएका किरणले नजिकै रहेको...

कसैले माग्दैमा खुरुक्क राजीनामा दिन्नँ : झलनाथ खनाल
काठमाडौं । नेकपा एकीकृत समाजवादीका सम्मानित नेता झलनाथ खनालले नेकपा एमालेसँग गरेको विद्रोहको औचित्य साबित गर्न नसके स्वतः गलत हुने बताएका छन् । शनिवार पत्रकार सम्मेलनमा उनले पार्टी अध्यक्ष माधवकुमार नेपालले ‘पार्टी छाडेर जान’ भनेपछि उनले भने ‘हामीले ...

प्रधानमन्त्री र मन्त्रीहरूले पाए आफ्नो तलब आफैँ तोक्ने अधिकार
काठमाडौं । प्रधानमन्त्री र मन्त्रीहरूलाई आफ्नो तलब र सुविधा आफैँ तोक्ने अधिकार दिइएको छ । सङ्घीय संसद्ले ‘केही नेपाल ऐन संशोधन विधेयक’ पारित गरेपछि मन्त्रिपरिषद्ले तलब निर्धारण गर्ने अधिकार पाएको हो । राष्ट्रपति रामचन्द्र पौडेलले साउन १४ गते यो विधेय...

शिवलाई चाम्लिङ् भन्ने ओलीले आफूलाई कुन दिन ब्रह्म घोषणा गर्छन् : हरि ढकाल
काठमाडौं । राष्ट्रिय स्वतन्त्र पार्टी (रास्वपा) का नेता हरि ढकालले प्रधानमन्त्री केपी शर्मा ओलीमाथि तीखो टिप्पणी गर्दै उनलाई ‘ब्रह्म’ को संज्ञा दिने दिन नजिकै रहेको टिप्पणी गरेका छन् । शनिवार इटहरी उपमहानगरपालिकाको नगर अधिवेशन उद्घाटन समारोहमा बोल्दै...

समृद्धिको सपना पूरा गर्न दृढताका साथ अघि बढ्नुपर्छ : ओली
काठमाडौं । प्रधानमन्त्री केपी शर्मा ओलीले वाम-लोकतान्त्रिक आन्दोलनका अग्रज र सहिदहरूका सङ्कल्पलाई दृढतापूर्वक पूरा गर्नुपर्ने बताएका छन् । तुल्सीलाल स्मृति प्रतिष्ठानले आयोजना गरेको २८ औँ तुल्सीलाल स्मृति दिवस कार्यक्रममा बोल्दै प्रधानमन्त्री ओलीले द...

बाजुरामा बाटोमै सुत्केरी
काठमाडौं । बाजुराको स्वामीकार्तिक खापर गाउँपालिकामा १८ वर्षीया सूचना दमाईलाई प्रसव वेदना लागेपछि उनी स्वास्थ्य संस्थातर्फ हिँडिन् । तर, आधा घण्टा पैदल हिँडेर लेम्ना पुग्दा व्यथाले च्यापेपछि उनी अघि बढ्न सकिनन् । गाउँका दुई महिलाको सहयोगमा हिँडेकी सूच...

पर्रोहा बोलबम धामको ज्योर्तिलिङ्गमा जलार्पण गर्नेको घुइँचो
लुम्बिनी । नेपालको एकमात्र स्वयं उत्पत्तिमान शिव ज्योर्तिलिङ्ग मानिने रूपन्देहीको पर्रोहा बोलबम धाममा दर्शनार्थीको घुइँचो लागेको छ । यहाँ हरेक वर्ष श्रावणी मेलामा जलार्पणका लागि दर्शनार्थीको ठूलो भीड लाग्ने गर्छ । विशेष गरी साउन महिनाभरि पहेँलो बस्त...

सुनकोशी नदीमा हामफालेर एक जना बेपत्ता
काभ्रेपलाञ्चोक । सुनकोशी नदीमा हामफाल्दा तेमाल गाउँपालिका-३, सरमथली माझीटोलका ७० वर्षीय गणेश माझी बेपत्ता भएका छन् । जिल्ला प्रहरी कार्यालय काभ्रेपलाञ्चोकका अनुसार शनिवार दिउँसो मलुवा भन्ने स्थानबाट उनले नदीमा हामफालेका थिए । प्रत्यक्षदर्शी स्थानीय...

पार्टी फुट्दैन, एकीकृत समाजवादी र नेकपासँग एकता गर्छौं : वर्षमान पुन
काठमाडौं । नेकपा (माओवादी केन्द्र) का उपमहासचिव वर्षमान पुनले अध्यक्ष पुष्पकमल दाहाल ‘प्रचण्ड’ र उपमहासचिव जनार्दन शर्माबीचको अन्तरविरोधले पार्टी विभाजन नहुने बताएका छन् । शनिवार स्थायी समिति बैठकपछि सञ्चारकर्मीसँग कुरा गर्दै उनले पार्टीभित्रका मतभेद...

‘देश समृद्ध बनाउन जोखिम मोलेरै काम गर्नुपर्छ’
काठमाडौं । नेपाल कम्युनिष्ट पार्टी (एमाले) का महासचिव शङ्कर पोखरेलले देश समृद्ध बनाउन जोखिम मोलेरै काम गर्न सक्नुपर्ने बताएका छन् । रिटर्नी फेडेरेशन नेपालले केही स्वदेशी लगानीकर्ताको सामूहिक लगानीमा स्थापना गरिएको ‘नवयुग इन्भेष्टमेन्ट कम्पनी लिमिटेड’...

नेपाली एमएमए फाइटर रविन्द्र ढाँट भारतमा चुंगरेंग कोरेनसँग भिड्दै
काठमाडौं । नेपाली मिश्रित मार्शल आट्र्स (एमएमए) फाइटर रविन्द्र ढाँटले आज भारतको ग्रेटर नोएडास्थित शहीद विजय सिंह पाठक स्पोट्र्स कम्प्लेक्समा आयोजना हुने म्याट्रिक्स फाइट नाइट एमएमए १७ को मुख्य इभेन्टमा भारतका चुंगरेंग कोरेनसँग ब्याम्टमवेट च्याम्पियनश...

जेन्जी पुस्तालाई कांग्रेससँग जोड्न आवश्यक : शेखर कोइराला
विराटनगर । नेपाली कांग्रेसका नेता डा.शेखर कोइरालाले युवा (जेन्जी) पुस्तालाई कांग्रेससँग नजोडे पार्टीको भविष्य सङ्कटमा पर्ने चेतावनी दिएका छन् । उनले कांग्रेस कमजोर भए लोकतन्त्र नै कमजोर हुने बताए । कोइरालाले लोकतन्त्र बिना नेपाली जनताको भविष्य असम्भव...

बागमतीका मुख्यमन्त्री लामाले आइतबार सशर्त राजीनामा दिने
काठमाडौं । बागमती प्रदेशका मुख्यमन्त्री बहादुरसिंह लामाले आइतबार सशर्त राजीनामा दिने भएका छन् । नेपाली कांग्रेसका सभापति शेरबहादुर देउवासँग शनिवार बूढानीलकण्ठमा भएको छलफलमा लामाले आफूले नियुक्त गरेका मन्त्रीहरूलाई निरन्तरता दिने सर्तमा राजीनामा दिन स...

संखुवासभा र तेह्रथुमको सिमानामा बस दुर्घटना हुँदा १४ घाइते
संखुवासभा । यहाँको धर्मदेवी नगरपालिका–९ मुलगाउँबाट दमक जाँदै गरेको बस दुर्घटना हुँदा १४ जना घाइते भएका छन् । बा २ प ७२४४ नम्बरको बस सङ्खुवासभा र तेह्रथुमको सिमानामा पर्ने लालीगुराँस नगरपालिका–१ स्थित देउराली घुम्तीमा सडकदेखि करिब १० मिटर तल खसेको जिल...

आगामी उपनिर्वाचनदेखि नै विदेशबाट मतदानको व्यवस्था गर्न रास्वपाको माग
काठमाडौं । राष्ट्रिय स्वतन्त्र पार्टी (रास्वपा)ले आगामी उपनिर्वाचनदेखि नै विदेशमा रहने नेपालीका लागि मतदानको व्यवस्था सुनिश्चित गर्न माग गरेको छ । शनिबार निर्वाचन आयोगले आयोजना गरेको सर्वदलीय छलफलमा रास्वपाका सहमहामन्त्री तथा लुम्बिनी प्रदेश इन्चार्ज...

मोटरसाइकल दुर्घटनामा एकको मृत्यु, दुई घाइते
धरान (सुनसरी) । सुनसरीको दुहबी नगरपालिका–२ पचिरामा मोटरसाइकल दुर्घटना हुँदा एक जनाको मृत्यु भएको छ भने दुई जना गम्भीर घाइते भएका छन् । शुक्रबार राति करिब ९ः१० बजे सुनसरीको दुहबीमा को६प ५२४१ नम्बरको मोटरसाइकल र को३२प १५०४ नम्बरको मोटरसाइकल एकापसमा ठोक...

कैलालीमा एक किशोरीको हत्या
धनगढी । कैलालीमा एक युवतीको हत्या भएको छ । १७ वर्षीया किशोरी याचना सेजवालको आज बिहान चक्कु प्रहार गरी हत्या भएको प्रहरीले जनाएको छ । बर्दगोरिया गाउँपालिका–३ घर भएकी उनी राजधानी सेकुवा एण्ड मःम सेन्टरमा काम गर्दै आएकी थिइन् । सेजवाललाई सोही सेकुवा सेन...

भारत पुर्याइएका ७ किशोरीको उद्धार
झापा । वैदेशिक रोजगारीको बहानामा भारत पु–याइएका सात नेपाली किशोरीलाई सीमावर्ती पानीटङ्की नाकाबाट भारतीय प्रहरीले उद्धार गरेको छ । ती किशोरीहरुलाई भारत पु–याउने दुई पुरुषलाई मानव तस्करी गरेको अभियोगमा भारतीय प्रहरीले पक्राउ गरेको माइती नेपालको कोशी प्...

चितवनको लोथरमा पेट्रोलियम पदार्थ भण्डारण गृह निर्माण गरिने
चितवन । यहाँको लोथर खोला र राप्ती दोभानको किनारमा पेट्रोलियम पदार्थ भण्डारण गृह निर्माण गरिने भएको छ । सो स्थानमा अमलेखगञ्ज–लोथर पेट्रोलियम पाइपलाइन विस्तार गरी भण्डारण गृह निर्माण गरिने भएको हो । भण्डारण गृह बनाउन राप्ती नगरपालिका–१ मा २३ विगाहा १२ ...

‘चयनमुखी’ अभियोजनले उत्पन्न गराएको बेचैनी
काठमाडौं । भ्रष्टाचारसम्बन्धी तहगत फैसलामा न्यायालयप्रति अख्तियार दुरुपयोग अनुसन्धान आयोगको असन्तुष्टि रहँदै आएको छ । अझ विशेष अदालतले प्रमाण हुँदा पनि त्यसलाई बेवास्ता गरेको भन्दै अख्तियार पटकपटक सर्वोच्च अदालतमा पुनरावेदन जाने गरेको छ । अख्तियारले ...

प्रहरीले भन्यो- आपराधिक क्रियाकलाप विरुद्धको ‘अपरेशन’ रोकिँदैन
काठमाडौं । प्रहरीले आपराधिक क्रियाकलापविरुद्धको अभियान नरोक्ने स्पष्ट पारेको छ । जिल्ला प्रहरी परिसर काठमाडौँका प्रमुख, प्रहरी वरिष्ठ उपरीक्षक विश्व अधिकारीले गुण्डाहरूको गतिविधि निस्तेज पार्न काठमाडौंभरि नै अपरेशन जारी रहेको बताए । ‘गुण्डाहरूले टाउक...
बागलुङका १२५ खानेपानी मुहानमा ‘कोलिफर्म’
बागलुङ । बागलुङमा बर्सेनि खानेपानीको मुहानमा दिसामा पाइने जीवाणु (कोलिफर्म) भेटिएको छ । प्रदेश जनस्वास्थ्य कार्यालय बागलुङले जिल्लाका दश वटै पालिकाका ३४१ मुहानको पानी परीक्षण गर्दा १२५ मुहानमा कोलिफर्म फेला परेको हो । जिल्लामा सबैभन्दा बढी जैमिनी नगर...

माओवादीको स्थायी समिति बैठक आज पनि बस्दै
काठमाडौं । नेकपा माओवादी केन्द्रको स्थायी समिति बैठक आज पनि बस्दैछ । पार्टी केन्द्रीय कार्यालय पेरिसडाँडाँमा शनिबार बिहान ११ बजेबाट बैठक सुरू हुने पार्टी प्रवक्ता तथा उपाध्यक्ष अग्नि सापकोटाले जानकारी दिए । आजको बैठकमा स्थायी समिति सदस्यहरूले धारणा र...

रुसलाई ट्रम्पको चेतावनी- आणविक पनडुब्बीहरू तैनाथ गर्न आदेश दिएको छु
काठमाडौं । अमेरिकी राष्ट्रपति डोनाल्ड ट्रम्पले आणविक पनडुब्बीहरू तैनाथ राख्न आफूले निर्देशन दिएको बताएका छन् । अन्तर्राष्ट्रिय मिडियाहरुका अनुसार रुसी सुरक्षा परिषद प्रमुख दिमित्री मेदवेदेवको धम्कीपछि ट्रम्पले रुसलाई यस्तो चेतावनी दिएका हुन् । ट्रम्प...

एमाले नेतृत्व बिद्यासँग किन थुरथुर ?
लोकतन्त्रको अर्को नाम हो– बहस र स्वस्थ्य प्रतिस्पर्धा । हाल नेपाल सरकार अर्थात नेकपा एमाले रातभर नसुती सातै प्रदेशका पार्टी इन्चार्ज र अध्यक्षहरुलाई सरकारी सेवासुबिधा तथा खानपानसहित प्रधानमन्त्री निवास बालुवाटार बैठकमा राखेर एमालेकी पूर्वउपाध्यक्ष क....

तेलको मूल्य घट्दा ‘एक्सनमोबिल’को आम्दानीमा ठूलो झट्का
न्युयोर्क । अमेरिकास्थित ठूला पेट्रोलियम कम्पनीमध्ये एक ‘एक्सनमोबिल’ले चालु आर्थिक वर्षको दोस्रो त्रैमासमा आफ्नो नाफा २३ दशमलव चार प्रतिशतले घटेको जनाएको छ । कम्पनीले प्राप्त नाफा झरेर सात अर्ब एक करोड अमेरिकी डलर बराबरमा सीमित भएको हो । यसअघि गएको व...

भीमदत्त पन्त : विद्रोहदेखि विचारसम्मको जनयात्रा
कञ्चनपुर । जीवनमा धेरै कुरा अनिश्चित भए पनि मृत्यु भने अटल सत्य हो । तर, केही व्यक्तित्व यस्ता हुन्छन्, जसको जीवनको अन्त्यले होइन, उनले गरेका कर्मले समाजमा अमिट छाप छोड्दछ । यस्ता महान् व्यक्तित्वमध्ये एक हुन, क्रान्तिकारी किसान नेता भीमदत्त पन्त । स...

मध्यपहाडी लोकमार्गको सिन्धुली खण्ड अवरुद्ध
सिन्धुली । मध्यपहाडी लोकमार्गअन्तर्गत सिन्धुली खण्ड आज बिहानैदेखि अवरुद्ध भएको छ । सडकमा पहिरो र लेदो थुप्रिएपछि लोकमार्ग अवरुद्ध भएको हो । गोलञ्जोर गाउँपालिका–६ अकरेभिरमा लेदोका कारण लोकमार्ग अवरुद्ध भएको जिल्ला प्रहरी कार्यालय सिन्धुलीका प्रहरी नाय...

आज यी तीन प्रदेशमा भारी वर्षाको सम्भावना
काठमाडौँ । हाल देशभर मनसुनी वायुको प्रभाव रहेको छ । मनसुनको न्यून चापीय रेखा सरदर स्थानको थोरै उत्तरतर्फ अवस्थित रहेको मौसम पूर्वानुमान महाशाखाले जनाएको छ । आज दिउँसो देशभर साधारणतया बदली रहनेछ । गण्डकी प्रदेश र लुम्बिनी प्रदेशलगायत देशका पहाडी भू–भा...

जनाताले काङ्ग्रेस र कम्युनिस्टको विकल्प खोजिरहेका छन् : कमल थापा
काठमाडौं । राप्रपा नेपालका अध्यक्ष कमल थापाले नेपाली राजनीति व्यापारीकरणसँगै भ्रष्टीकरण भएको बताएका छन् । शुक्रवार पार्टीको उपत्यकास्तरीय विस्तारित बैठकलाई सम्बोधन गर्दै थापाले सङ्घीयता, धर्मनिरपेक्ष गणतन्त्रको मार्गचित्र र विचार असफल भएको बताए । अहि...

रुकुम पूर्वको सदरमुकाम रुकुमकोट तोक्नुको कारण पेस गर्न सर्वोच्चको आदेश
काठमाडौं । सर्वोच्च अदालतले रुकुम पूर्वको सदरमुकाम रुकुमकोट तोक्ने सरकारी निर्णयविरुद्ध परेको रिटमा कारण देखाऊ आदेश जारी गरेको छ । न्यायाधीश कुमार रेग्मीको एकल इजलासले रुकुम पूर्वका प्रमुख राजनीतिक दलका स्थानीय, प्रदेश र सङ्घीय जनप्रतिनिधिहरूले दायर...

जुलाईमा भित्रिए ७० हजार विदेशी पर्यटक
काठमाडौं । सन् २०२५ को जुलाई महिनामा नेपालले कूल ७० हजार एक सय ९३ जना विदेशी पर्यटकलाई स्वागत गरेको छ । यो सङ्ख्या अघिल्लो वर्षको जुलाई महिनाको तुलनामा ८.७ प्रतिशतले बढी हो । नेपाल पर्यटन बोर्डका अनुसार, महामारीपूर्वको अवस्था सन् २०१९ को अप्रिल महिना...

४८ शाखा अधिकृतको सरूवा, काे कहाँ ?
काठमाडौं । सङ्घीय मामिला तथा सामान्य प्रशासन मन्त्रालयले शुक्रवार ४८ शाखा अधिकृतको सरुवा गरेको छ । मन्त्रालयले शुक्रवार स्थानीय तहमा कामकाज गर्ने गरी अधिकृतहरूको सरुवा गरेको हो । उनीहरूमध्ये केहीलाई प्रमुख प्रशासकीय अधिकृत र केहीलाई शाह अधिकृतको रूपम...

पाकिस्तानका प्रहरी चेकपोस्टमाथि सशस्त्र आक्रमण, पाँच प्रहरीको मृत्यु
पाकिस्तान । पाकिस्तानको पूर्वी प्रान्त पञ्जाबको रहिम यार खान जिल्लामा सशस्त्र समूहहरूले प्रहरी चेकपोस्टमा गरेको आक्रमणमा कम्तीमा पाँच जना प्रहरीको ज्यान गएको छ । प्रहरी अधिकारीहरूले शुक्रवार दिएको जानकारी अनुसार, एलीट फोर्सले निगरानी गरिरहेको चेकपोस्...

इलाममा १०२ जनाले पाए आमाको नामबाट नागरिकता
इलाम । आर्थिक वर्ष २०८१/८२ मा इलामका एक सय दुई जनाले आमाको नामबाट नेपाली नागरिकताको प्रमाणपत्र प्राप्त गरेका छन् । जिल्ला प्रशासन कार्यालय इलाम, इलाका प्रशासन कार्यालय मङ्गलबारे र अध्यागमन तथा सीमा प्रशासन कार्यालय पशुपतिनगरबाट एक सय दुई जनाले आमाको ...

नेपालले पार्टी छाड्न भनेपछि झलनाथले भने-‘तानाशाही प्रवृत्ति देखाउने’
काठमाडौं । नेपाल कम्युनिस्ट पार्टी (एकीकृत समाजवादी) भित्रको आन्तरिक कलह सतहमा आएको छ । पार्टीका सम्मानित नेता तथा पूर्वप्रधानमन्त्री झलनाथ खनाल र अध्यक्ष माधवकुमार नेपालबीचको तीव्र आरोप-प्रत्यारोपले पार्टीभित्र गहिरो सङ्कटको सङ्केत गरेको छ । खनालले ...

मर्नु न बाँच्नु अवस्थामा कृषक
नेपाल कृषि प्रधान देश हो भन्ने कुरा जगजाहेर नै छ । किनभने सानो कक्षामा पढ्दा नै रटाइएको वाक्य हो- ‘नेपाल कृषिप्रधान देश हो ।’ तर, यो वाक्य आजको दिनमा विडम्बना बन्न थालेको छ । जलवायु परिवर्तन, नीति विहीनता र सहायताविहीन राज्य संयन्त्रले किसान देशको ‘स...

नाउपाः चमत्कारी उदय, श्रीमान-श्रीमतीको इगोले अस्तित्व संकटमा
काठमाडौं । मधेस आन्दोलन तीव्र रूपमा उठिरहेको बेलामा राज्यको उपेक्षा गरेको भन्दै २०७२ सालमा थारु समुदायमा सुरु भएको थारुहठ आन्दोलनबाट रेशम चौधरी उदाएका थिए । टीकापुर घटनापछि चौधरीलाई दोषी ठहर गरिँदा कैलालीका थारु समुदाय राज्यप्रति अझ आक्रोशित बने । र,...

अमलेखगन्ज-लोथर पेट्रोलियम पाइपलाइन निर्माण सुरु
चितवन । बाराको अमलेखगन्जदेखि चितवनको लोथरसम्म पेट्रोलियम पाइपलाइन विस्तार गर्ने कार्य अघि बढेको छ । नेपाल आयल निगमले आज लोथरमा परियोजनाको फिल्ड कार्यालय स्थापना गरेर दोस्रो चरणको पेट्रोलियम पाइपलाइन विस्तारको काम सुरु गरेको हो । राप्ती नगरपालिका–१ लो...

‘भात छैन थालमा, राहत छैन हातमा !’
काठमाडौं । सरकारले मधेशलाई सुख्खा सङ्कटग्रस्त क्षेत्र घोषणा गरेपनि दिर्घकालीन योजना नल्याएको भन्दै काठमाडौंमा प्रदर्शन गरिएको छ । सुख्खाग्रस्त क्षेत्र घोषणा गरेर सङ्घ सरकार र प्रदेश सरकार डिप बोरिङ गाड्ने जस्ता अल्पकालीन योजनामा लागेको भन्दै युवाहरूल...

लागूऔषधविरुद्ध निर्मम रूपमा प्रस्तुत हुनुपर्छ : गृहमन्त्री लेखक
काठमाडौं । गृहमन्त्री रमेश लेखकले लागूऔषधको उत्पादन, ओसारपसार, भण्डारण र सेवनले समाजमा गम्भीर चुनौती खडा गरेको बताउँदै यसविरुद्ध प्रहरी कर्मचारीहरू निर्मम रूपमा प्रस्तुत हुनुपर्नेमा जोड दिए । शुक्रवार लागूऔषध नियन्त्रण ब्यूरो, कोटेश्वरको निरीक्षण भ्र...

स्थायी कमिटीमा प्रचण्डको १० बुँदे ब्रिफिङ : ‘सार्वजनिक रूपमा नेतृत्वको आलोचना नगर्नु’
काठमाडौं । नेकपा माओवादी केन्द्रका अध्यक्ष पुष्पकमल दाहाल ‘प्रचण्ड’ले सरकार बनाउने-भत्काउने खेलमा नलागी सङ्गठन सुदृढीकरणमा ध्यान केन्द्रित गर्नुपर्ने बताएका छन् । शुक्रवारदेखि सुरु भएको स्थायी कमिटी बैठकमा उनले १० बुँदे ब्रिफिङमार्फत पार्टीको आन्तरिक...

‘एमाले विभाजन गर्ने नेताहरू पछुतोमा, कार्यकर्तालाई घर फर्कन आह्वान’
काठमाडौं । नेकपा (एमाले)का महासचिव शङ्कर पोखरेलले पार्टी विभाजनका कारण एमाले जनताको पहिलो रोजाइको पार्टी भएर पनि परिणाममा नेपाली कांग्रेसपछि दोस्रो बन्नुपरेको बताएका छन् । शुक्रवार पार्टी केन्द्रीय कार्यालयमा आयोजित पार्टी प्रवेश कार्यक्रममा बोल्दै उ...

चक्रे मिलनसहित १९ जनालाई ७ दिन हिरासतमा राख्न अनुमति
काठमाडौं । गुण्डा नाइके चक्रे मिलन उर्फ मिलन गुरुङको जन्मदिन पार्टीबाट पक्राउ परेका १९ जनालाई ७ दिन हिरासतमा राखेर अनुसन्धान गर्न जिल्ला प्रशासन कार्यालय, काठमाडौंले अनुमति दिएको छ । महाराजगञ्जको एक होटलबाट पक्राउ परेका ४७ मध्ये २८ जनालाई प्रहरीले छा...

राजनीतिक हस्तक्षेपले स्वास्थ्य संस्था सङ्कटमा परे : शेखर कोइराला
काठमाडौं । नेपाली कांग्रेसका नेता डा. शेखर कोइरालाले प्रधानमन्त्री कार्यालय र स्वास्थ्य तथा जनसङ्ख्या मन्त्रालयको अनावश्यक हस्तक्षेपका कारण स्वास्थ्य संस्थाहरू सङ्कटमा परेको बताएका छन् । धरानस्थित बीपी कोइराला स्वास्थ्य विज्ञान प्रतिष्ठानका सन् २००० ...

रुख ढल्दा टौवामा ओत लागेका दुई जनाको मृत्यु, तीन घाइते
काभ्रपलाञ्चोक । सिन्धुलीको हरिहरपुरगढी गाउँपालिका–१ बस्तीपुरमा रुख ढल्दा दुई जनाको मृत्यु भएको छ भने तीनजना बालबालिका घाइते भएका छन् । जिल्ला प्रहरी कार्यालय सिन्धुलीका अनुसार आज शुक्रवार दिउँसो ३:३० बजेतिर झरीका कारण ओत लाग्न बसेको टौवामा सालको ठूलो...

घट्दै कोदोखेती, बाझिँदै बारी
पाल्पा । एक दश अघिसम्म यहाँका गामीण भेगका सबैजसो ठाउँमा कोदो लगाइन्थ्यो । बारीमा कोदो राम्रै उब्जनी हुन्थ्यो । तर अहिले गाउँमा यसको बीउसम्म पनि पाउन मुस्किल पर्न थालेको छ । ग्रामीण भेगमा कोदो खेतीले ढाकिने बारी अहिले बाझिँदै गएका छन् । कोदोको महत्त्...

एकीकृत समाजवादीसँग छिट्टै पार्टी एकता हुन्छ : प्रचण्ड
काठमाडौं । नेकपा माओवादी केन्द्रका अध्यक्ष पुष्पकमल दाहाल प्रचण्डले नेकपा एकीकृत समाजवादीसँगको एकता प्रक्रिया सकारात्मक भएको बताएका छन् । केन्द्रीय कार्यालय पेरिसडाँडामा शुक्रवार बसेको स्थायी समिति बैठकमा पार्टी एकता प्रक्रिया सकारात्मक भएको बताए । ...

राज्यले प्राथमिकता नदिएसम्म विपद्जन्य क्षति न्यूनिकरण प्रभावकारी हुँदैन : आईजीपी
काठमाडौं । सशस्त्र प्रहरी बल, नेपालका महानिरीक्षक राजु अर्यालले राज्यको लगानी र नीतिमा विपद् प्राथमिकताको विषय नपरेसम्म विपद्जन्य क्षति न्यूनिकरण प्रभावकारी बन्न नसक्ने बताएका छन् । शुक्रवार सशस्त्रले आयोजना गरेको विपद् सम्बन्धी अन्तरक्रिया एवं छलफलम...

बागमती प्रदेश पूर्ण खोपयुक्त घोषणा
भक्तपुर । बागमती प्रदेशलाई पूर्ण खोप घोषणा गरिएको छ । प्रदेशका १३ जिल्ला र ११९ पालिका पूर्ण खोप भएपछि प्रदेशस्तरमा घोषणा गरिएको हो । प्रदेशको स्वास्थ्य मन्त्रालयद्वारा आयोजित कार्यक्रममा प्रधानमन्त्री ओलीले सो घोषणा गरेका हुन् । संघ सरकारको स्वास्थ्...

अब सवारी चालक लाइसेन्सको अवधि १० वर्ष
काठमाडौं । सवारी चालक अनुमतिपत्र (लाइसेन्स) को बहाल अवधि १० वर्ष पुगेको छ । सरकारले केही नेपाल ऐन संशोधन गर्न बनेको विधेयक राजपत्रमा प्रकाशित गरेसँगै बहाल अवधि १० वर्ष पुगेको हो । जस अनुसार सवारी तथा यातायात व्यवस्था ऐन २०४९ मा रहेको लाइसेन्स अवधि ५...

माधव नेपालले झलनाथलाई भने-‘पार्टीमा बस्ने अधिकारै छैन, राजीनामा दिनुस्’
काठमाडौं । नेकपा (एकीकृत समाजवादी)का अध्यक्ष माधवकुमार नेपालले पार्टीका नेता झलनाथ खनाललाई राजीनामा दिएर पार्टीबाट बिदा हुन सुझाव दिएका छन् । खनालले निरन्तर पार्टी नीतिविपरीत अभिव्यक्ति दिएको भन्दै नेपालले खनाललाई पार्टीमा बस्ने नैतिक अधिकार नरहेको ब...

ट्रम्पको धम्कीपछि युक्रेनमा रुसी ड्रोन र क्षेप्यास्त्रको वर्षा : २६ जना मारिए
किएभ । युक्रेनको किएभमा बिहीबार भएको रुसी क्षेप्यास्त्र र ड्रोन हमलामा तीन बालबालिकासहित २६ जनाको मृत्यु भएको युक्रेनको आन्तरिक मन्त्रालयले जनाएको छ । यसअघि दुई बालबालिका सहित १६ जनाको मृत्यु भएको जनाएकोमा ‘उद्धारकर्ताहरूले स्वाटोसिन्स्की जिल्लाको आव...

बर्दघाटमा यात्रुबाहक बस पल्टिँदा १ जनाको मृत्यु, १३ घाइते
बुटवल । बुटवल-नारायणगढ सडकखण्ड अन्तर्गत बर्दघाटमा यात्रुबाहक बस पल्टिएको छ । बुटवलबाट नारायणगढतर्फ जाँदै गरेको लु २ ख ६५७ नम्बरको बस नवलपरासीको बर्दघाट नगरपालिका-५ शान्तिनगर चोकमा पल्टिँदा १ जनाको मृत्यु भएको छ भने १३ जना घाइते भएका छन् । प्रहरीका अन...

झाँगिदै सम्बन्धविच्छेद
पाल्पा । यहाँको बगनासकाली गाउँपालिकाकी एक युवतीले दुई वर्षअघि २१ वर्षको उमेरमा अन्तरजातीय विवाह गरिन् तर उनको दाम्पत्य जीवन तीन वर्ष पनि टिक्न सकेन । एक सन्तानकी आमा उनी विवाह भएको दुई वर्ष पुग्दा नपुग्दै खटपट सुरु भयो। उनलाई श्रीमान् र घरपरिवारबाट घ...

युवा सूचना प्रविधिको क्षेत्रमा अब्बल हुनुपर्छ : सञ्चारमन्त्री गुरुङ
काठमाडौं । सञ्चार तथा सूचना प्रविधिमन्त्री पृथ्वी सुब्बा गुरुङले अबका युवाले सूचना प्रविधिको क्षेत्रमा अब्बल भई सिर्जनात्मक भविष्य बनाउनमा जोड दिनुपर्ने बताएका छन् । काठमाडौंमा आज कान्तिपुर सिटी कलेजमा आयोजित ‘केसिसी एक्जिविसन-२०२५’ को उद्घाटन गर्द...

ओलीले गर्दा देशले पीडा पायो : नेपाल
विराटनगर । नेकपा एकीकृत समाजवादीका अध्यक्ष एवं पूर्वप्रधानमन्त्री माधवकुमार नेपालले एमाले अध्यक्ष केपी शर्मा ओलीको दम्भ र अहंकारका कारण देशले पीडा भोगिरहेको बताएका छन् । शुक्रवार विराटनगर विमानस्थलमा सञ्चारकर्मीसँग कुरा गर्दै उनले अहिलेको सरकार सबै ...

इमरान खानको पार्टीका एक सय ८ जनालाई जेल सजाय
काठमाडौं । पाकिस्तानले जेलमा रहेका पूर्वप्रधानमन्त्री इमरान खानको पार्टीका एक सय ८ सदस्यलाई जेल सजाय सुनाएको छ । उनीहरूलाई सन् २०२३ मा सेना विरुद्धको विरोध प्रदर्शनमा भाग लिएको आरोप लगाइएको छ । मे २०२३ मा सुरक्षा बलले भ्रष्टाचारको आरोपमा अदालतमा उप...

प्रधानमन्त्री आइतबार तुर्कमेनिस्तान जाँदै
काठमाडौं । प्रधानमन्त्री केपी शर्मा ओली आइतबार तुर्कमेनिस्तान जाने भएका छन् । भूपरिवेष्ठित विकासशील देशहरू सम्बन्धी तेस्रो राष्ट्रसंघीय सम्मेलनमा सहभागी हुन नेपाली प्रतिनिधिमण्डलको नेतृत्व गर्दै उनी तुर्कमेनिस्तान जान लागेका हुन् । तुर्कमेनिस्तानका र...

माओवादीको स्थायी समिति बैठक सुरू, प्रत्येक सदस्यलाई १५ मिनेट समय
काठमाडौं । नेकपा (माओवादी केन्द्र)को स्थायी समिति बैठक सुरु भएको छ । बैठक केन्द्रीय कार्यालय परिसडाँडामा केहि बेरअघिबाट सुरु भएको हो । बैठकको प्रारम्भमा सहिदप्रति श्रद्धाञ्जली व्यक्त गर्दै अध्यक्ष पुष्पकमल दाहाल प्रचण्डले एजेण्डा पेस गरेका छन् । जसमा...

बागमतीका मुख्यमन्त्री राजीनामा दिन तयार
काठमाडौं । बागमती प्रदेशका मुख्यमन्त्री बहादुरसिंह लामा पदबाट राजीनामा दिन तयार भएका छन् । बिहीबारको भेटमा नेपाली कांग्रेसका सभापति शेरबहादुर देउवाले राजीनामा दिन निर्देशन दिएपछि मुख्यमन्त्री लामा राजीनामा दिने निर्णयमा पुगेका हुन् । देउवाले बिहीबार ...

आजदेखि खुला आँगन कार्यक्रम सुरु गर्दै रास्वपा
काठमाडौं । राष्ट्रिय स्वतन्त्र पार्टी (रास्वपा) ले आजदेखि खुला आँगन कार्यक्रम प्रारम्भ गर्दैछ । प्रत्यक्ष जनसम्पर्क तथा पार्टी नेतृत्व र नागरिकबीच खुला संवादको संस्कार विकास गर्ने उद्देश्यका साथ रास्वपाले यो कार्यक्रम सुरु गर्न लागेको हो । महामन्त्री...

कोदोको उत्पादन वृद्धि गर्न प्रधानमन्त्रीको आग्रह
काठमाडौं । प्रधानमन्त्री केपी शर्मा ओलीले कोदो हाम्रो परम्परागत खाद्यान्न बाली मात्र नभई यसको पोषणीय महत्व रहेको बताएका छन् । कोदो दिवसका अवसरमा आज सामाजिक सञ्जालमार्फत शुभकामना व्यक्त गर्दै प्रधानमन्त्री ओलीले कोदोको उत्पादन बढाउन र परिकारहरु उपभोग ...

खटाएको ठाउँमा नगएका २३ कर्मचारीलाई गृहको २४ घण्टे अल्टिमेटम
काठमाडौं । गृह मन्त्रालयले २३ जना कर्मचारीलाई २४ घण्टाभित्र सरूवा तथा पदस्थापन गरेको ठाउँमा हाजिर हुन निर्देशन दिएको छ । गृहले शुक्रबार २३ जनाको सूची सार्वजनिक गर्दै २४ घण्टाभित्र सरूवा गरेको स्थानमा हाजिर हुन भनेको हो । ती कर्मचारीहरू मध्ये १८ जना श...

आलोचकलाई ओली-प्रचण्डले सफाया गर्न थाले : बाबुराम
काठमाडौं । नेपाल समाजवादी पार्टी (नयाँ शक्ति) का अध्यक्ष डा. बाबुराम भट्टराईले प्रधानमन्त्री तथा नेकपा एमाले अध्यक्ष केपी शर्मा ओली र माओवादी केन्द्रका अध्यक्ष पुष्पकमल दाहाल प्रचण्डमाथि गम्भीर आरोप लगाएका छन् । शुक्रबार सामाजिक सञ्जाल फेसबुकमा स्टाट...

चक्रे मिलन समूहको गाडीबाट २ वटा खुकुरी र रड बरामद
काठमाडौं । प्रहरीले चक्रे मिलन भनिने मिलन गुरुङ समूहको गाडीबाट खुकुरी र रड बरामद गरेको छ । बुधबार राति महाराजगञ्जस्थित होटल साम्बालाबाट बर्थडे केक काट्दै गरेको अवस्थामा पक्राउ परेका चक्रे मिलनसहित ४७ जनाको यो समूहको गाडीबाट खुकुरी र रड बरामद भएको हो ...

किन पक्राउ परे चक्रे मिलनसहित ४७ जना ?
काठमाडौं । पछिल्लो समय चुपचाप जस्तै रहेका चक्रे मिलन भनेर चिनिने मिलन गुरूङ गएराति पक्राउ परे । करिब १ बजेतिर महाराजगञ्जस्थित साम्वाला होटलमा होहल्लासहित म्युजिकको तालमा बर्थडे मनाइरहेका उनीसहित ४७ जना पक्राउ परेका हुन् । उनीहरुलाई पक्राउ गर्न प्रहरी...

माओवादीको बैठकमा १ जनालाई १० मिनेट बोल्न दिइने
काठमाडौं । नेकपा माओवादी केन्द्रको स्थायी समिति बैठकमा एक जनालाई १० मिनेट बोल्न दिने भएको छ । दिउँसो १ बजे पार्टी कार्यालय पेरिसडाँडामा बस्ने बैठकमा एक जनालाई १० मिनेट बोल्न दिने तयारी भएको हो । उपमहासचिव हरिबोल गजुरेलले बोल्न चाहाने सबै सदस्यहरुलाई ...

कोदालोको पासोले हानेर श्रीमतीको हत्या, श्रीमान पक्राउ
काठमाडौं । पाँचथरको फिदिममा श्रीमान्ले कोदालोको पासोले हान्दा श्रीमतीको मृत्यु भएको छ । गएराति फालेलुङ–७ घर भएका २७ वर्षीय महेन्द्र तामाङले पारिवारिक विवादमा ससुराली घर नजिकै कोदालोको पासोले हान्दा श्रीमती २२ वर्षीय अनु राईको ज्यान गएको हो । कोदालो प...

मुख्यमन्त्री लामालाई पदत्याग गर्न आग्रह
हेटौंडा । नेपाली कांग्रेस वाग्मती प्रदेश संसदीय दलका नेता इन्द्रबहादुर बानियाँले मुख्यमन्त्री बहादुरसिंह लामा तामाङलाई राजीनामा दिएर मार्गप्रशस्त गर्न आग्रह गरेका छन् । केही दिनअघि संसदीय दलको नेतामा निर्वाचित हुनुभएका बानियाँले आज बिहान सञ्चारकर्मीस...

नेतृत्व हस्तान्तरणको चिन्ता
७० वर्ष उमेर कटिसकेका प्रधानमन्त्री केपी शर्मा ओली आफू जवान नै रहेको दाबी गर्छन् । सत्ताको शक्तिले जुन जोस दिन्छ त्यसले उनलाई जवान देखिन मन लाग्नु स्वाभाविक नै हो । सामान्य पारिवारिक पृष्ठभूमिबाट अनायासै राजनीतिमा लागेका ओलीले अहिलेको स्थान बनाउन निक...

निजी विद्यालयमाथिको दबाबले शिक्षा क्षेत्र संकटमा पर्न सक्छ : प्याब्सन
काठमाडौं । राष्ट्रिय निजी तथा आवासीय विद्यालय एसोसिएसन नेपाल (नेसनल प्याब्सन)ले संविधान, शिक्षा ऐन र कानुनको दायरामा रही सञ्चालनमा रहेका निजी विद्यालयहरूलाई नजिकिँदो कानुनी तथा प्रशासनिक दबाबका कारण शैक्षिक भविष्य अन्योलमा पर्न सक्ने भन्दै गम्भीर चिन...

नेपाल–चीन दौत्य सम्बन्ध ७०औँ वर्षमा
काठमाडौं । आजदेखि नेपाल–चीन कूटनीतिक सम्बन्ध ७० औँ वर्षमा प्रवेश गरेको छ । यस अवसरमा आज काठमाडौं र बेइजिङमा विविध कार्यक्रम आयोजना गरेर कूटनीतिक सम्बन्ध स्थापनाको ७० औँ वार्षिकोत्सव मनाइँदै छ। अनौपचारिक रूपमा तिब्बतका राजा स्रोङ्चन गम्पोसँग राजकुमारी...

बागमतीका मुख्यमन्त्रीलाई राजीनामा दिन बानियाँको आग्रह
काठमाडौं । नेपाली कांग्रेस बागमती प्रदेश संसदीय दलका नेता इन्द्रबहादुर बानियाँले मुख्यमन्त्री बहादुरसिंह लामा तामाङलाई राजीनामा दिएर मार्गप्रशस्त गर्न आग्रह गरेका छन् । केही दिनअघि संसदीय दलको नेतामा निर्वाचित भएका बानियाँले आज बिहान सञ्चारकर्मीसँग क...

आज २८ जिल्लामा आकस्मिक बाढीको जोखिम
काठमाडौं । जल तथा मौसम विभागअत्तर्गतको बाढी पूर्वानुमान महाशाखाले आज विभिन्न २८ जिल्लामा बाढी आउने सम्भावना रहेको भन्दै सतर्क रहन आग्रह गरेको छ । महाशाखाले बुलेटिन जारी गर्दै आज बझाङ, अछाम, सुर्खेत, दैलेख, जाजरकोट र आसपासका जिल्ला भई बहने केही ससाना ...

रुपन्देही-३ उपनिर्वाचनका लागि दल दर्ता गर्न आह्वान
काठमाडौं । निर्वाचन आयोगले आगामी कात्तिक १७ गते रुपन्देही निर्वाचन क्षेत्र नं ३ मा हुने उपनिर्वाचनका लागि दल दर्ता गर्न सबै राजनीतिक दललाई आह्वान गरेको छ । आयोगले आज एक सूचना जारी गर्दै यही साउन २१ देखि २७ गतेसम्म आयोगका केन्द्रीय कार्यालयमा दल दर्ता...

माओवादीको स्थायी समिति बैठक बस्दै, ७ एजेन्डामा छलफल हुने
काठमाडौं । नेकपा (माओवादी केन्द्र) को स्थायी समिति बैठक आज बस्दैछ । बैठक दिउँसो १ बजे पार्टी कार्यालय पेरिसडाँडामा बस्ने भएको हो । आजदेखि चार दिनसम्म चल्ने बैठकमा उपमहासचिव जनार्दन शर्माले उठाएकासहित ७ एजेन्डामाथि छलफल हुने सचिव देवेन्द्र पौडेलले जान...

अमेरिकी सेना र राष्ट्रपतिको अस्पतालमा बन्दूकधारी छिरेको हल्लापछि…
वासिंगटन । अमेरिकी सैनिक र अमेरिकी राष्ट्रपतिको उपचार गर्ने वासिङ्टन बाहिरको वाल्टर रिड अस्पताल बिहीबार केही समयका लागि बन्द गर्नुपरेको छ । मेरिल्यान्डको मोन्टगोमरी काउन्टीमा रहेको प्रहरीले सामाजिक सञ्जालमा भनेको छ, ‘अधिकारीहरूले नक्कली बन्दुक बोकेका...

ट्रम्पले घोषणा गरे भन्सारको नयाँ दर, कुन देशलाई कति ? (सूची)
एजेन्सी । अमेरिकाले व्यापार साझेदार देशहरुका लागि नयाँ भन्सार दर तोकेको छ । गएराति अमेरिकी राष्ट्रपति डोनाल्ड ट्रम्पले व्यापार साझेदार देशहरूका लागि भन्सारको नयाँ दर तोकिएको कार्यकारी आदेशमा हस्ताक्षर गरेका हुन् । ट्रम्पले नयाँ घोषणा गरेको भन्सार दर ...

पहिरोले मध्य पहाडी राजमार्ग अवरुद्ध
काठमाडौं । पहिरोले मध्य पहाडी राजमार्ग अवरुद्ध भएको छ । गएराति जाजरकोट छेडागाड नगरपालिका–३ दंखेरी भिर गिट्टिखोलामा पहिरो खस्दा मध्य पहाडी राजमार्ग अवरुद्ध भएको हो । प्रहरीका अनुसार पहिरो झरेर सडक पुरिँदा राजमार्गमा सवारी आवगमन ठप्प भएको भएको छ । अवरु...

आज पहिलोपटक राष्ट्रिय कोदो दिवस मनाइँदै
काठमाडौं । सरकारले कोदोजन्य बालीहरूको आयात रोक्न, उत्पादन तथा उत्पादकत्व बढाउने उद्देश्यले पहिलोपटक आज राष्ट्रिय कोदो दिवस मनाउँदैछ । कोदोजन्य बालीले साना किसानको आयआर्जन बढाउन, खाद्य तथा पोषण सुरक्षाका लागि आज साउन १६ गते दिवस मनाउन लागिएको हो । कृष...

ईन्धनको मूल्य समायोजन : पेट्रोलको घट्यो, हवाई ईन्धनको बढ्यो
काठमाडौं । नेपाल आयल निगमले पेट्रोलको मूल्य घटाएको छ । पेट्रोलको भाउ घटाएपनि मट्टितेल र हवाई ईन्धनको मूल्य भने बढाएको छ । इन्डियन आयल कर्पोरेशनबाट पेट्रोलियम पदार्थको नयाँ मूल्य सूची प्राप्त भएको भन्दै पेट्रोल, डिजेल, मट्टितेल र हवाई इन्धनको मूल्य गए...

क्यानले एनपीएलबाट कमायो २७ करोड ६९ लाख
काठमाडौं । नेपाल क्रिकेट संघ (क्यान)ले नेपाल प्रिमियर लिग (एनपीएल)बाट २७ करोड ६९ लाख बढी आम्दानी गरेको छ । बिहीबार मूलपानीमा बसेको क्यानको केन्द्रीय कार्यसमिति बैठकले एनपीएलको पहिलो संस्करणबाट प्राप्त आय–व्ययको विवरणको सार्वजनिक गरेको हो । जसमा एनपीए...

इकोसकको अध्यक्षमा नेपाल निर्वाचित
काठमाडौं । नेपाल संयुक्त राष्ट्रसङ्घीय आर्थिक तथा सामाजिक परिषद् (इकोसक) को अध्यक्षमा निर्वाचित भएको छ । परिषदमा बिहीबार निर्वाचित भएसँगै नेपालले कार्यभार पनि सम्हालेको छ । संयुक्त राष्ट्रसङ्घका लागि नेपालका स्थायी प्रतिनिधि लोकबहादुर थापाले परिषद्को...

यस्तो छ आज शुक्रबारको लागि विदेशी मुद्राको विनिमयदर
काठमाडौं । नेपाल राष्ट्र बैंकले आजका लागि विदेशी मुद्राको विनिमयदर निर्धारण गरेको छ । राष्ट्र बैंकका अनुसार अमेरिकी डलर एकको खरिददर १३९ रुपैयाँ ८६ पैसा र बिक्रीदर १४० रुपैयाँ ४६ पैसा निर्धारण गरिएको छ । युरोपियन युरो एकको खरिददर १५९ रुपैयाँ ९९ पैसा र...

चक्रे मिलनको ‘बर्थडे पार्टी’मा प्रहरी छापा, ४७ जना पक्राउ
काठमाडौं । प्रहरीले गण्डागर्दीमा संलग्न चक्रे मिलन (मिलन गुरुङ)सहित ४७ जना भन्दा बढीलाई पक्राउ गरेको छ । गएराति ठमेल र महाराजगन्ज क्षेत्रबाट प्रहरीले उनीहरुलाई पक्राउ गरेको हो । चक्रे मिलनको ‘बर्थडे पार्टी’मा गुण्डागर्दीमा संलग्न व्यक्तिहरु भेला भएको...

आज चारवटा संसदीय समितिको बैठक बस्दै
काठमाडौं । संघीय संसद्मातहतका विभिन्न चारवटा संसदीय समितिको बैठक बस्दैछ । निर्धारित समयअनुसार आज कृषि, सकारी तथा प्राकृतिक स्रोत समिति, शिक्षा, स्वास्थ्य तथा सूचना प्रविधि समिति, विधायन व्यवस्थापन समिति र सङ्घीयता सबलीकरण तथा राष्ट्रिय सरोकार समितिको...

आज बागमती प्रदेशमा भारी वर्षा हुने पूर्वानुमान
काठमाडौं । जल तथा मौसम पूर्वानुमान महाशाखाले आज देशभर साधारणतया बदली रहने जनाएको छ । महाशाखाका अनुसार आज दिउँसो कोशी, लुम्बिनी, कर्णाली र सुदूरपश्चिम प्रदेशका पहाडी भागका धेरै तथा तराई भेगका केही स्थानमा मेघगर्जन र चट्याङसहित मध्यम वर्षाको सम्भावना छ...

मधेसमा सङ्कटसँगै बढ्यो सुनकोशी मरिणको औचित्य
पर्सा । मुलुकको अन्न भण्डारको रूपमा परिचित तराई–मधेस अहिले सुक्खाग्रस्तको सङ्कटबाट गुज्रिरहेको छ । पर्याप्त मात्रामा अकासेपानी नपरेपछि यहाँका कतिपय जिल्लामा धानको रोपाइँ हुन सकिरहेका छैनन् । रोपाइँ भएका ठाउँमा पनि अत्यधिक चर्को गर्मीले रोपो जोगाउन स...

सामाजिक सञ्जालमार्फत जनार्दन शर्माको प्रतिकार गर्न खुमलटारमै ‘वार रूम’
काठमाडौं । नेकपा (माओवादी केन्द्र) भित्रको आन्तरिक विवाद चर्किँदै जाँदा पार्टी अध्यक्ष पुष्पकमल दाहाल ‘प्रचण्ड’ को सचिवालयले नेतृत्वको बचाउ गर्न खुमलटारबाट सामाजिक सञ्जालमार्फत विरोधीविरुद्ध अभियान सुरु गरेको छ । पार्टी उपमहासचिव जनार्दन शर्माले नेत...

चितवनमा स्क्रब टाइफस सङ्क्रमण बढ्दो, एक वर्षमा एक हजार ५५ सङ्क्रमित
नारायणगढ । चितवनमा गत आर्थिक वर्षमा स्क्रब टाइफस परीक्षण गरिएका बिरामीमध्ये एक हजार ५५ जनामा सङ्क्रमण पुष्टि भएको छ । जिल्ला जनस्वास्थ्य कार्यालय, चितवनले सार्वजनिक गरेको तथ्यांकअनुसार सो अवधिमा एक जनाको स्क्रब टाइफसका कारण मृत्यु भएको पुष्टि भएको छ ...

तेहरानमा पानीको सङ्कट
तेहरान । इरानका राष्ट्रपति मसूद पेजेस्कियानले पानीको खपत नरोकिए केही महिनाभित्रै राजधानी तेहरानमा रहेका बाँधहरू सुक्न सक्ने चेतावनी दिएका छन् । ‘यदि तेहरानमा हामीले स्थितिलाई व्यवस्थापन गर्न सकेनौँ, तेहरानबासीले हामीलाई सहयोग गरेनन् र हामी उपभोग नियन...

सुदूरपश्चिमका मुख्यमन्त्री शाहले पाए विश्वासको मत
काठमाडौं । सुदूरपश्चिमका मुख्यमन्त्री कमल बहादुर शाहले विश्वासको मत पाएका छन् । बिहीबार अपराह्न ५ बजेको प्रदेशको सभाको छैटौँ अधिवेशनको २० औँ बैठकमा शाहले विश्वासको मत पाएका हुन् । संविधानको धारा १८८ को उपधारा १ र २ व्यवस्था अनुरूप दोस्रो पटक मुख्यमन्...

मार्गदर्शन सहकारी ठगी : एमाले नेता सिलवाल पक्राउ
काठमाडौं । मार्गदर्शन सहकारीको रकम अपचलन गरेको आरोपमा कलेज सञ्चालक रामहरि सिलवाल पक्राउ परेका छन् । रुपन्देहीको भैरहवास्थित मार्गदर्शन बहुउद्देश्यीय सहकारी संस्था लिमिटेडबाट करिब ६ करोड रकम हिनामिना गरेको आरोपमा सिलवाल उपत्यका अपराध अनुसन्धान कार्या...

सिद्धान्तको मुखौटा, सत्ताको तमासा
अहिले माओवादी आन्दोलनको पछिल्लो गतिविधि हेर्दा प्रचण्ड र प्रभाकर नामका दुई उपनाम र त्यसको अनुहार एउटै सिक्काका दुई पाटा भनेझैँ सत्ता र शक्तिको लफडामा गाँजिएर ‘क्रान्ति’ शब्दलाई रगडिरहेका छन् । यो जुहारी केवल दुई नेताको हैसियतको जुधाइ होइन, हजारौँ क्र...